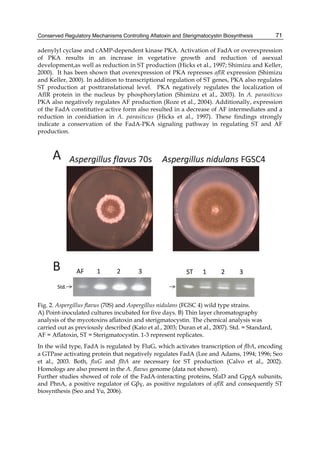
Conserved Regulatory Mechanisms Controlling Aflatoxin and Sterigmatocystin Biosynthesis 
71 
adenylyl cyclase and cAMP-dependent kinase PKA. Activation of FadA or overexpression 
of PKA results in an increase in vegetative growth and reduction of asexual 
development,as well as reduction in ST production (Hicks et al., 1997; Shimizu and Keller, 
2000). It has been shown that overexpression of PKA represses aflR expression (Shimizu 
and Keller, 2000). In addition to transcriptional regulation of ST genes, PKA also regulates 
ST production at posttranslational level. PKA negatively regulates the localization of 
AflR protein in the nucleus by phosphorylation (Shimizu et al., 2003). In A. parasiticus 
PKA also negatively regulates AF production (Roze et al., 2004). Additionally, expression 
of the FadA constitutive active form also resulted in a decrease of AF intermediates and a 
reduction in conidiation in A. parasiticus (Hicks et al., 1997). These findings strongly 
indicate a conservation of the FadA-PKA signaling pathway in regulating ST and AF 
production. 
Fig. 2. Aspergillus flavus (70S) and Aspergillus nidulans (FGSC 4) wild type strains. 
A) Point-inoculated cultures incubated for five days. B) Thin layer chromatography 
analysis of the mycotoxins aflatoxin and sterigmatocystin. The chemical analysis was 
carried out as previously described (Kato et al., 2003; Duran et al., 2007). Std. = Standard, 
AF = Aflatoxin, ST = Sterigmatocystin. 1-3 represent replicates. 
In the wild type, FadA is regulated by FluG, which activates transcription of flbA, encoding 
a GTPase activating protein that negatively regulates FadA (Lee and Adams, 1994; 1996; Seo 
et al., 2003. Both, fluG and flbA are necessary for ST production (Calvo et al., 2002). 
Homologs are also present in the A. flavus genome (data not shown). 
Further studies showed of role of the FadA-interacting proteins, SfaD and GpgA subunits, 
and PhnA, a positive regulator of Gβγ, as positive regulators of aflR and consequently ST 
biosynthesis (Seo and Yu, 2006).

This chapter discusses the biotransformation of aflatoxin B1 (AFB1) and its relationship to the differential toxicological response in commercial poultry species. AFB1 is highly toxic to most animal species, though some are more susceptible than others. The toxic effects of AFB1 are dose- and time-dependent, and can cause acute or chronic aflatoxicosis. While AFB1 exposure primarily damages the liver in poultry, different species vary in their sensitivity, from most sensitive (ducklings) to less sensitive (chickens). Differences in biotransformation of AFB1, specifically variations in cytochrome P450-mediated metabolism, may contribute to this differential toxicity between p



















![10
Both biotransformation variables (AFBO formation and AFB1 disappearance) correlate well
with the in vivo sensitivity observed for turkeys, quail and chickens (turkeys being highly
sensitive, chickens being the most resistant and quail having intermediate sensitivity).
However, other factor(s) besides AFBO formation and AFB1 consumption must play a role
in the extraordinary high sensitivity of ducks to AFB1 because these biochemical variables
did not correlate with the in vivo sensitivity for this particular species [ducks exhibit the
highest in vivo sensitivity to AFB1 among these poultry species, not turkeys, as Rawal et al.
(2010a) affirm].
The cytosolic metabolism of AFB1 in the same four poultry species shows a different trend
compared with the microsomal metabolism (Fig. 3). Turkeys are again the largest producers
of the cytosolic metabolite AFL but are followed by ducks, chickens and quail (instead of
quail, ducks and chickens as it is observed for microsomal metabolism). As discussed before
(see section 2.1.4), AFL is a toxic metabolite of AFB1 and it cannot be considered a
detoxication product; therefore, it would be expected that sensitive species produce more
AFL than resistant ones. However, no correlation between AFL production and in vivo
sensitivity was observed. For instance, quail produced the lowest amount of AFL and it
exhibits intermediate sensitivity to AFB1, while ducks, which are the most sensitive species,
produced much less AFL than turkeys. AFB1 consumption by cytosol (rate of AFB1
disappearance from cytosolic incubations) was highest for the chicken, followed by turkeys,
ducks and quail and there was no correlation between AFL formation and AFB1
consumption (Fig. 3). Further, as it was observed for AFL formation, there was no
correlation between AFB1 disappearance from cytosol and in vivo sensitivity to AFB1.
Investigation of the potential conjugation reactions of AFL might clarify the role of AFL
formation on the in vivo sensitivity to AFB1 in poultry. It is possible that the high resistance
of chickens to AFB1 might be due to an efficient reduction of AFB1 to AFL followed by
conjugation and elimination of the AFL conjugate. Interestingly, it has been demonstrated
that chick liver possesses much higher AFB1 reductase activity than duckling or rat liver
(Chen et al., 1981).
Aflatoxins – Biochemistry and Molecular Biology
0,7
0,6
0,5
0,4
0,3
0,2
0,1
0
0,25
0,20
0,15
0,10
0,05
0,00
AFL production
AFB1 consumption
Turkey Quail Duck Chicken
AFB1 consumption (nmol AFB1 consumed/mg
proten/minute)
AFL production (nmol AFL/mg protein/minute)
Avian species
Turkey
Quail
Duck
Chicken
0,25
0,20
0,15
0,10
0,05
0,00
0,0 0,1 0,2 0,3 0,4 0,5 0,6 0,7
AFL production (nmol AFL/mg protein/minute)
AFB1 consumption (nmol AFB1 consumed/mg
protein/minute)
Fig. 3. AFL production and AFB1 consumption in turkey, quail, duck and chicken
cytosolic incubations (left) and relationship between AFL formation and AFB1
consumption (right).](https://image.slidesharecdn.com/aflatoxins-biochemistryandmolecularbiology-141124075246-conversion-gate01/85/aflatoxinas-20-320.jpg)
























![Control of Aflatoxin Biosynthesis in Aspergilli
35
Among these are genes predicted to encode a protein kinase, an opsin homolog [a protein
that may bind a photoreactive chromophore (Shichida & Matsuyama, 2009)], an integrin-repeat
protein, and a calcium-binding protein. Since mycelial growth is unaffected in these
mutants it is possible that the treatments affect proper formation of the vesicles necessary
for AF biogenesis. Furthermore, other genes predicted to encode membrane-bound proteins
are proteins involved in transport or exocytosis: a GPI (glycosylphosphatidylinositol)-
anchored protein a GABA permease, a MFS transporter. Downregulation of expression of
genes encoding membrane-bound proteins described above could explain the loss of normal
development of asexual structures required for proper conidial formation and this
phenotypic change in the mutant cells could prevent the formation of the vesicle needed for
AF biogenesis (Chanda et al., 2009).
5. Protein turnover and its effect on AF biosynthesis
Another form of regulation that takes place post-translationally is control of transcription
factor abundance by targeted degradation. Obviously if a transcription factor critical for a
particular function is targeted for degradation, it no longer would be available for regulation
of expression. As alluded to previously, some of the AflR proteins made by some Aspergillus
species have PEST domains that may make these proteins destined for ubiquitin-mediated
degradation (Rechsteiner, 1988). Ubiquitination is controlled by specialized ubiquitin ligases
that reside in organelles called proteasomes. Another organelle related to the proteasome is
called the COP9 Signalosome (CSN) (Busch et al., 2003). This multiprotein complex can both
stabilize or destabilize other proteins by attaching or detaching a small protein (Nedd8) in a
process called neddylation or deneddylation at the protein’s ubiquitination site. The CSN
complex also contains kinases that affect the activity of other regulatory factors.
In A. nidulans the COP9 signalosome was found to be a key regulator of light-dependent
signaling and asexual and sexual development (Busch et al., 2003; He et al., 2005). The
Aspergillus COP9 signalosome may control the abundance of the transcription factors that
regulate these processes. Mutation of genes encoding csnD and csnE (components of CSN)
(Busch et al., 2003) affects normal development in A. nidulans and pigmentation. In these
mutants the abnormal mycelial pigmentation suggests that CSN regulates processes in both
fungal development and secondary metabolism. When LaeA was used as the bait in a yeast
two-hybrid assay with an A. parasiticus cDNA expression library as the prey, among the
proteins binding to LaeA was COP9 signalosome complex subunit 5 (XM_001211499) (K.
Ehrlich and B. M. Mack, unpublished data). This further suggests that the activity of LaeA
may be modulated by specific interactions with CSN.
6. Conclusions
Expression of the genes in the AF biosynthesis cluster is mainly controlled by the pathway
specific Cys6Zn2 DNA binding protein, AflR. While AflR appears to be necessary for the
activation, a number of coactivators are important for fine-tuning of the timing of AflR’s
activity. These proteins, AflJ, LaeA, VeA, VelB and VosA, may form a complex in the nucleus
to not only position AflR at the AF cluster genes but also alter the chromatin conformation in
this locus in order to allow AflR and global transcriptional regulatory proteins to make contact
with the basal transcription machinery. They may do this concomitantly with AflR binding or
act to recruit AflR to the cluster. AflR expression is induced by simple sugars and inhibited by
certain organic acids and aldehydes. Globally acting DNA-binding proteins are involved in](https://image.slidesharecdn.com/aflatoxins-biochemistryandmolecularbiology-141124075246-conversion-gate01/85/aflatoxinas-45-320.jpg)

![Conserved Regulatory Mechanisms Controlling Aflatoxin and Sterigmatocystin Biosynthesis
77
VeA-interacting proteins, initially characterized in A. nidulans. For these reasons these
protein complexes constitute potential targets for control strategies to reduce the production
of AF and possibly mycotoxin production in other fungi.
Although there are some disparities in the regulation of ST and AF, most of the control
mechanisms governing the synthesis of these mycotoxins are conserved. A. nidulans is an
excellent model organism to elucidate the complexity of these regulatory networks and
provide insight in remediating the impact of AF contamination.
7. References
Adrio, J. L., and A. L. Demain. 2003. Fungal biotechnology. International Microbiology 6
(3):191-199.
Amaike, S., and N. P. Keller. 2009. Distinct Roles for VeA and LaeA in Development and
Pathogenesis of Aspergillus flavus. Eukaryotic Cell 8 (7):1051-1060.
Andrianopoulos, A., S. Kourambas, J. A. Sharp, M. A. Davis, and M. J. Hynes. 1998.
Characterization of the Aspergillus nidulans nmrA gene involved in nitrogen
metabolite repression. Journal of Bacteriology 180 (7):1973-1977.
Araujo-Bazan, L., S. Dhingra, J. Chu, J. Fernandez-Martinez, A. M. Calvo, and E. A. Espeso.
2009. Importin alpha is an essential nuclear import carrier adaptor required for
proper sexual and asexual development and secondary metabolism in Aspergillus
nidulans. Fungal Genetics and Biology 46 (6-7):506-515.
Arst, H. N., and D. J. Cove. 1973. Nitrogen metabolite repression in Aspergillus-nidulans.
Molecular & General Genetics 126 (2):111-141.
Atoui, A., D. P. Bao, N. Kaur, W. S. Grayburn, and A. M. Calvo. 2008. Aspergillus nidulans
natural product biosynthesis is regulated by mpkB, a putative pheromone response
mitogen-activated protein kinase. Applied and Environmental Microbiology 74
(11):3596-3600.
Atoui, A., C. Kastner, C. M. Larey, R. Thokala, O. Etxebeste, E. A. Espeso, R. Fischer, and A.
M. Calvo. Cross-talk between light and glucose regulation controls toxin
production and morphogenesis in Aspergillus nidulans. Fungal Genetics and Biology
47 (12):962-972.
Baidya, S., J. W. Cary, W. S. Grayburn, and A. M. Calvo. 2011. Role of nitric oxide and
flavohemoglobin homologous genes in Aspergillus nidulans sexual development and
mycotoxin production. Applied Environmental Microbiology, June 3 [Epub ahead of
print]
Banuett, F. 1998. Signalling in the yeasts: An informational cascade with links to the
filamentous fungi. Microbiology and Molecular Biology Reviews 62 (2):249-+.
Bardwell, L. 2006. Mechanisms of MAPK signalling specificity. Biochemical Society
Transactions 34:837-841.
Bayram, O., S. Krappmann, M. Ni, J. W. Bok, K. Helmstaedt, O. Valerius, S. Braus-
Stromeyer, N. J. Kwon, N. P. Keller, J. H. Yu, and G. H. Braus. 2008.
VelB/VeA/LaeA complex coordinates light signal with fungal development and
secondary metabolism. Science 320 (5882):1504-1506.
Bayram, O., S. Krappmann, S. Seiler, N. Vogt, and G. H. Braus. 2008. Neurospora crassa ve-1
affects asexual conidiation. Fungal Genetics and Biology 45 (2):127-138.](https://image.slidesharecdn.com/aflatoxins-biochemistryandmolecularbiology-141124075246-conversion-gate01/85/aflatoxinas-87-320.jpg)














![92
need to continually identify and utilize additional sources of maize genotypes with
aflatoxin-resistance.
An important contribution to the identification/investigation of kernel aflatoxin-resistance
has been the development of a rapid laboratory screening assay. The kernel screening assay
(KSA), was developed and used to study resistance to aflatoxin production in GT-MAS:gk
kernels (Brown et al., 1993, 1995]. The KSA is designed to address the fact that aflatoxin
buildup occurs in mature and not developing kernels. Although, other agronomic factors
(e.g. husk tightness) are known to affect genetic resistance to aflatoxin accumulation in the
field, the KSA measures seed-based resistance. The seed, of course, is the primary target of
aflatoxigenic fungi, and is the edible portion of the crop. Therefore, seed-based resistance
represents the core objective of maize host resistance. Towards this aim, the KSA has
demonstrated proficiency in separating susceptible from resistant seed [Brown et al., 1993,
1995). This assay has several advantages, as compared to traditional field screening
techniques (Brown et al., 1995): 1) it can be performed and repeated several times
throughout the year and outside of the growing season; 2) it requires few kernels; 3) it can
detect/identify different kernel resistance mechanisms; 4) it can dispute or confirm field
evaluations (identify escapes); and 5) correlations between laboratory findings and
inoculations in the field have been demonstrated. The KSA can, therefore, be a valuable
complement to standard breeding practices for preliminary evaluation of germplasm.
However, field trials are necessary for the final confirmation of resistance.
One drawback to using the known resistant maize lines to develop commercial lines is their
poor agronomic quality (Brown et al., 1999). To overcome this, markers need to be identified
to facilitate the incorporation of aflatoxin-resistance into lines with commercially-acceptable
genetic backgrounds. The expression of maize kernel proteins has been implicated in kernel
resistance to A. flavus infection/aflatoxin production (Cordero et al., 1992, 1994; Guo, et al.,
1996; Huang et al., 1997). Using reverse genetics to identify genes that are associated with
aflatoxin-resistance may lead to the discovery of breeding markers. These protein/gene
markers could be used to transfer resistance to good genetic backgrounds while excluding
undesirable traits. The purpose of this review is to highlight the discovery of resistance-associated
Aflatoxins – Biochemistry and Molecular Biology
proteins (RAPs) and their potential as breeding markers.
2. Discovery of Resistance-Associated Proteins (RAPs)
The development of the KSA by Brown et al. (Brown et al., 1995) facilitated the verification
of maize kernel resistance under laboratory conditions in a short time. This accelerated the
discovery of knowledge surrounding host resistance mechanisms. Using this assay, Brown
et al. (Brown et al., 1993) discovered the existence of subpericarp resistance in maize kernels
and that the expression of this resistance requires a live embryo, the latter indicating a
potential role for kernel proteins in resistance. Guo et al. (1996) found that imbibition of
kernels, before inoculation with A. flavus, significantly increased aflatoxin-resistance of
susceptible maize genotypes. Further investigation revealed that susceptible genotypes were
able to induce antifungal proteins upon fungal infection (Guo et al., 1996), suggesting that
susceptible lines have the ability to induce an active defense mechanism after fungal
infection. The usefulness of the KSA as an investigative tool is aided by the fact that KSA
results correlate well with field results (Brown et al., 1995) and that aflatoxin buildup occurs](https://image.slidesharecdn.com/aflatoxins-biochemistryandmolecularbiology-141124075246-conversion-gate01/85/aflatoxinas-102-320.jpg)




![Identification of Gene Markers in
Aflatoxin-Resistant Maize Germplasm for Marker-Assisted Breeding
97
3. Characterization of RAPs
A literature review of the RAPs that have been identified indicates that storage and stress-related
proteins may play important roles in enhancing stress tolerance of host plants. The
expression of storage protein GLB1 and LEA3 has been reported to be stress-responsive and
ABA-dependant (Thomann et al., 1992). Transgenic rice overexpressing a barley LEA3
protein HVA1 showed significantly increased tolerance to water deficit and salinity (Xu et
al., 1996).
The role of GLX I (Table 2) in stress-tolerance was first highlighted in an earlier study using
transgenic tobacco plants overexpressing a Brassica juncea glyoxalase I (Veena et al., 1999).
The substrate for glyoxalase I, methylglyoxal, is a potent cytotoxic compound produced
spontaneously in all organisms under physiological conditions from glycolysis and
photosynthesis intermediates, glyceraldehydes-3-phosphate and dihydroxyacetone
phosphate. Methylglyoxal is an aflatoxin inducer even at low concentrations; experimental
evidence indicates that induction is through upregulation of aflatoxin biosynthetic pathway
transcripts including the AFLR regulatory gene (Chen et al., 2004). Therefore, glyoxalase I
may be directly affecting resistance by removing its aflatoxin-inducing substrate,
methylglyoxal.
PER1, a 1-cys peroxiredoxin antioxidant identified in a proteomics investigation (Chen et al.,
2007a), was demonstrated to be an abundant peroxidase (Table 2), and may play a role in
the removal of reactive oxygen species. The PER1 protein overexpressed in Escherichia coli
demonstrated peroxidase activity in vitro. It is possibly involved in removing reactive
oxygen species produced when maize is growing under stress (Chen et al., 2007a).
Another RAP that has been characterized further is the pathogenesis-related protein 10
(PR10) (Table 2). It showed high homology to PR10 from rice (85.6% identical) and sorghum
(81.4% identical). It also shares 51.9% identity to intracellular pathogenesis-related proteins
from lily (AAF21625) and asparagus (CAA10720), and low homology to a RNase from
ginseng [48]. The PR10 overexpressed in E. coli exhibited ribonucleolytic and antifungal
activities. In addition, an increase in the antifungal activity against A. flavus growth was
observed in the leaf extracts of transgenic tobacco plants expressing maize PR10 gene
compared to the control leaf extract (Chen et al., 2006). This evidence suggests that PR10
plays a role in kernel resistance by inhibiting fungal growth of A. flavus. Further, its
expression during kernel development was induced in the resistant line GT-MAS:gk, but not
in susceptible Mo17 in response to fungal inoculation (Chen et al., 2006). Recently, a new
PR10 homologue was identified from maize (PR10.1) (Xie et al., 2010). PR10 was expressed
at higher levels in all tissues compared to PR10.1, however, purified PR10.1 overexpressed in
E. coli possessed 8-fold higher specific RNase activity than PR10 (Xie et al., 2010). This
homologue may also play a role in resistance.
Evidence supporting a role for PR10 in host resistance is also accumulating in other plants.
A barley PR10 gene was found to be specifically induced in resistant cultivars upon
infection by Rhynchosporium secalis, but not in near-isogenic susceptible plants (Steiner-
Lange et al., 2003). In cowpea, a PR10 homolog was specifically up-regulated in resistant
epidermal cells inoculated with the rust fungus Uromyces vignae Barclay (Mould et al., 2003).
A PR10 transcript was also induced in rice during infection by Magnaporthe grisea (McGee et
al., 2001).
To directly demonstrate whether selected RAPs play a key role in host resistance against A.
flavus infection, an RNA interference (RNAi) vector to silence the expression of endogenous](https://image.slidesharecdn.com/aflatoxins-biochemistryandmolecularbiology-141124075246-conversion-gate01/85/aflatoxinas-107-320.jpg)









![6
Biomarkers of Aflatoxin Exposure and Its
Relationship with the Hepatocellular Carcinoma
Alessandra Vincenzi Jager, Fernando Silva Ramalho,
Leandra Náira Zambelli and Carlos Augusto Fernandes Oliveira
Universidade de São Paulo
Brazil
1. Introduction
Mycotoxins are secondary metabolites produced by fungi that grow naturally in foodstuffs.
They are able to generate a wide variety of toxic effects in vertebrates, including men
(Coulombe, 1991). Toxigenic fungi may contaminate foodstuffs in the most different phases
of production and processing, from cultivation to transport and storage. Mycotoxins show
high chemical stability and may persist in the foodstuff even after fungi were removed by
common manufacturing and packaging processes (Chu, 1991).
Diseases caused by mycotoxins are called mycotoxicoses. They are diffuse syndromes that
cause lesions mainly in organs such as liver, kidneys, epithelial tissue (skin and mucous
membranes) and central nervous system, depending on the type of the toxin. Two or more
toxins may also occur simultaneously, leading to intensified toxic effects on the susceptible
organism (Orsi et al., 2007).
Aflatoxins are mycotoxins produced by fungi in the genus Aspergillus, species A. flavus, A.
parasiticus and A. nomius (Moss, 1998). These fungi are distributed worldwide, and their
optimal growth conditions are relative humidity of 80-85% and temperature around 30ºC
(Coulombe, 1991).
Nowadays, 18 similar compounds are called aflatoxins. However, the most important in
medical terms are types B1, B2, G1 e G2 (Coulombe, 1991). Aflatoxin B1 (AFB1), besides being
the most frequently found in plant substrates, has the greatest toxigenic power. Aflatoxins
B2 (AFB2), G1 (AFG1) and G2 (AFG2) have about 50, 20 and 10% of AFB1 toxigenic power,
respectively (Leeson et al., 1995).
AFB1 is a genotoxic compound, and is considered to be one of the most potent natural
mutagens. Liver carcinogenesis is the most important effect of chronic aflatoxin exposure. This
toxicity has been widely demonstrated – mainly in relation to AFB1 - in many animal species,
including fish, birds, rodents, carnivores and primates (Busby & Wogan, 1984). Based on
available studies, the International Agency for Research on Cancer (IARC) concluded, in 1987, that
there was enough evidence to classify AFB1 in Group 1 - human carcinogen (Rothschild, 1992)
One of the most important aspects in risk analysis of chemical substances is to determine the
degree of human exposure (World Health Organization [WHO], 2002), a particularly
difficult task for contaminants present in foodstuffs. However, it is possible to indirectly
estimate the degree of exposure based on data on consumption of contaminated foodstuffs,
and on the average occurrence of the toxin. In this estimation, the degree of exposure is](https://image.slidesharecdn.com/aflatoxins-biochemistryandmolecularbiology-141124075246-conversion-gate01/85/aflatoxinas-117-320.jpg)






















![130
2.1 Sample preparation strategies in fungal proteomics
The aim of the sample preparation in proteomics is the effective extraction of all expressed
proteins from an organism or tissue with the possible highest efficiency, by solubilizing
them. Without appropriate extraction and solubilisation, further separation and analysis of
proteins is definitely not possible and the proteomics approach will fail (Posch 2008).
Especially in fungal proteomics, to our experiences, the appropriate sample preparation
plays a key role in protein extraction from the cell. Filamentous fungi contain a rigid cell
wall and the extraction of intracellular proteins is therefore difficult. The cell wall is
involved in many important functions, such as physical protection, osmotic stability,
selective permeability barrier, immobilized enzyme transport, cell to cell interactions, and
morphogenesis. Additionally, the cell wall is involved in virulence, pathogenicity,
antigenicity, immunomodulation and adhesion to host substrate in pathogen fungi (Chaffin
et al., 1998). Most of the studies were reported on the cell wall of Saccharomyces cerevisiae (De
Groot et al., 2005; Klis et al., 2006; Ruiz-Herrera et al., 2006), which is generally composed of
glucans (with β-1,3 and β-1,6 linkage), chitin (N-acetylglucosamine polymers), and proteins.
These proteins are often highly O- and/or N-mannosylated leading to an elevated
complexity (Pitarch et al., 2008). Generally, the cell wall proteins are very difficult to analyze
due to their low solubility, hydrophobic nature and low quantity.
Cell lysis is necessary in order to extract the intracellular proteins from filamentous fungi.
There are numerous cell lysis protocols used for extraction of proteins, which include: grinding
with liquid nitrogen using mortar and pestle (Hernandez-Macedo et al., 2002; Grinyer et al.,
2005; Shimizu & Wariishi 2005; Shimizu et al., 2005; Fernandez-Acero et al., 2006; Kniemeyer et
al., 2006; Yajima & Kav 2006), mechanical grinding using glass beads (Nandakumar & Marten
2002), chemical lysis (Riezman et al., 1983), and enzymatic lysis (Conzelmann et al., 1988). In a
review by Nandakumar & Marten, different lysis methods were compared to extract
intracellular proteins of A. oryzae for 1-DE and 2-DE (Nandakumar & Marten 2002). The
authors tested four lysis cell protocols: (i) boiling in strong alkali, (ii) boiling in sodium dodecyl
sulfate (SDS), (iii) chemical lysis in Y-PER® reagent, and (iv) mechanical lysis via rapid
agitation with glass beads in a Mini-BeadBeater®. The authors reported that the “mechanical
lysis via rapid agitation with glass beads” method seems to be most suitable for the protein
extraction and showed good patterns on 1-DE and 2-DE gel electrophoresis.
Most of the protein extraction methods and lysis protocols applied to fungal proteomics
were overtaken from plant proteomics with some modifications. Mainly detergents like SDS
or 3-[(3-Cholamidopropyl) dimethylammonio]-1-propanesulfonate (CHAPS) as well as
chaotropic agents (urea and thiourea) in combination with a reducing agents such as DTT
are used. In order to prevent proteolytic degradation of proteins and thus, changes in the
proteome pattern, protease activity has to be inhibited. Consequently it is necessary to add
protease inhibitors to the lysis buffer. In general a combination of different protease
inhibitors in form of a cocktail is recommended. Furthermore, the addition of carrier
ampholytes improves the solubility of proteins (Westermeier et al., 2008).
Major proteins of Aspergillus ochraceus were extracted with the help of a mortar and pestle in
liquid nitrogen and were separated on 1-DE as well as 2-DE (Rizwan et al., 2010). Similarly,
intracellular proteins from A. fumigatus were extracted by mortar and pestle using liquid
nitrogen followed by brief sonication (Carberry et al., 2006).
Aflatoxins – Biochemistry and Molecular Biology
2.1.1 Protein precipitation
During the cell lysis other interfering substances like phospholipids and nucleic acids can be
co-extracted and will be visualized in the acidic part of the gel (Westermeier et al., 2008).](https://image.slidesharecdn.com/aflatoxins-biochemistryandmolecularbiology-141124075246-conversion-gate01/85/aflatoxinas-140-320.jpg)























![154
Given that the drought resistance or tolerance in maize is clearly a quantitative character
(Zarco et al., 2005). But, like tolerance to other abiotic stress, drought stress is controlled by
many minor genes (polygenes) that have additive effects in their expression (Thi Lang and
Chi Buu, 2008. The loci on chromosomes housing such types of genes are now referred to as
quantitative trait loci (QTL) (Ashraf, 2010). In a QTL analysis, phenotypic evaluation is
carried out in a large number of plants from a segregating population for a variety of genetic
markers. Then, the whole population, or only a part of it, is genotyped. Finally, appropriate
statistical analysis is performed to pinpoint the loci controlling a trait (Asins, 2002). Due to
the intricacy of the abiotic stress tolerance and the problems encountered in phenotypic
based selection, the QTL mapping has been considered as imperative to the use of DNA
markers for improving stress tolerance (Ashraf, 2010).
Natural genetic variation of a crop can be exploited either via direct selection under stressful
conditions (simulated or natural) or via mapping of QTL and subsequent marker-assisted
selection (Ashraf et al., 2008). QTL mapping allows assessing the locations, numbers,
magnitude of phenotypic effects, and pattern of gene action (Vinh and Paterson, 2005). The
role of polygenes in controlling a trait has been widely assessed by traditional means, but
the use of DNA markers and QTL mapping has made it convenient to dissect the complex
traits (Ashraf, 2010).
Recent molecular biology tools have undoubtedly led to the development of DNA markers
that have been effectively used to identify QTL a number of traits in different crops. Ashraf
et al. (2008) have listed a variety of DNA markers such as RFLPs, RAPDs, CAPS, PCRindels,
AFLPs, microsatellites (SSRs), SNPs, and DNA sequences being currently in use to examine
the inheritance of stress tolerance. QTL mapping for the drought tolerance trait has been
done in different crops, the most notable being maize, wheat, barley, cotton, sorghum, and
rice (Sari-Gorla et al., 1999; Ashraf, 2010).
Associations between markers and traits were first reported in maize by Stuber and Moll
(1972) using isozymes. The advent of abundant DNA-based molecular markers allowed the
construction of genetic maps. In maize, a linkage analysis between the manifestation of
some key characteristics like male and female flowering time, anthesis-silking interval, plant
height, and molecular markers [RFLP, microsatellites (SSR) and AFLP] was carried out
under different water regimes using a maize population consisting of 142 RILs derived from
selfing the F1 population from a cross B73×H99. Linkage analysis showed that, the QTL
identified for male flowering time and plant height were the same under well-watered and
water-stressed conditions (Sari-Gorla et al., 1999).
A marker-assisted backcross (MABC) selection program for improving grain yield under
water limited conditions in tropical maize was conducted at CIMMYT, Mexico, which
involved the crossing of drought resistant line Ac7643 with a drought susceptible line
CML247. Marker-based selection was carried out stepwise on all four generations (from
BC1F1 to BC2F3). After the four consecutive MABC cycles, the 70 BC2F3 individuals
exhibiting the closest allelic composition at target and non-target loci were bred with two
CIMMYT testers (CML254 and CML274). Thirty genotypes were selected on the basis of
their performance in terms of grain yield and some key agronomic traits. However, the best
five MABC-derived hybrids produced yield about 50% more than that of control hybrids,
but in contrast, under mild water stress, there was no difference between MABC-derived
hybrids and the control plants. This confirms that the expression of genetic variation for
drought tolerance mainly depends on the severity of drought stress (Ribaut and Ragot,
2007).
Aflatoxins – Biochemistry and Molecular Biology](https://image.slidesharecdn.com/aflatoxins-biochemistryandmolecularbiology-141124075246-conversion-gate01/85/aflatoxinas-164-320.jpg)























![178
[IARC], 1993; Ray-Chaudhuri et al., 1980). AFB1 can form adducts with DNA, RNA and
protein, which form the major basis of the health risks (Sun et al., 2001; Williams et al., 2004).
Epidemiological and experimental studies have implicated aflatoxins in male reproductive
health, and the present review is an attempt to put together the knowledge in a
comprehensive perspective.
2. Aflatoxins in sperm and semen
Aflatoxins or their metabolites can reach the testis (Bukovjan et al., 1992) and be present in
the semen through this route (Ibeh et al., 1994; Picha et al., 1986; Uriah et al., 2001).
Aflatoxins have been detected in boar sperm (Picha et al., 1986) and human semen (Ibeh et
al., 1994). In a cross sectional study, Ibeh et al., (1994) found a relationship between aflatoxin
levels in serum of infertile men compared to controls: 40% of semen from infertile men had
aflatoxins and 50% of spermatozoa were abnormal, whereas 8% of semen from fertile
individuals had aflatoxins and only 10-15% were abnormal. The concentrations of aflatoxins
detected in the semen were consistently higher among infertile compared to the fertile men.
This study was supported by experiments conducted in rats, and the results were in
agreement with the observations in the human samples. Uriah et al., (2001) reported
translocation of aflatoxin B1 in humans from blood to semen through the blood-testis
barrier. In the boars, the highest AF residues in sperm were recorded in March to May and
were related with aflatoxin concentration in the feed ration. The group of boars with fertility
disorder had more AF in their sperm (up to 100 pmol-1), lower sperm concentration,
impaired survival of spermatozoa and a large proportion of abnormal spermatozoa (Picha et
al.,1986). When ram epididymal sperm were put in different concentrations of aflatoxin, on
one-hour post-incubation in control group 81.25% of sperm cells were alive of which 82.88%
were motile. The lowest motility (15.93%) was observed in 62.5 ppb aflatoxin-exposed
sperm. Sperm viability did not change significantly after 2nd and 3rd hr incubation but
significantly decreased in 4th and 5th hr post- incubation. The results of the experiment
showed that aflatoxin could decrease motility of sperm obtained from ejaculation or
epididymis (Tajik et al., 2007). Ibeh et al., (2000) cultured oocytes for in vitro fertilization
(IVF) in IVF medium containing AFB1 and exposed to sperm cells. Epididymal sperm
capacitated in IVF medium, with or without AFB1, were exposed to oocytes. AFB1 exposure
significantly reduced the mean number of ova fertilized. Exposure of sperm to AF caused
significant reduction in their motility.
3. Some classical experimental studies on testicular effects of AFs
One of the earliest reports indicating impairment of reproductive efficiency due to AF
toxicity was that of Maryamma & Sivadas, (1975) who found that continuous feeding of a
diet containing 0.7 ppm AF produced testicular degeneration in male goats. Subsequently,
there have been other reports of AFB1 causing delay in physiological and behavioural sexual
maturation (Ottinger & Doerr, 1980) and also delayed testicular development in juvenile
Japanese quail (Doerr & Ottinger, 1980). Sharlin et al., (1980) found decreased semen
volumes and testes weights, and disruption of the germinal epithelium in mature male
white Leghorn chicks. Another study conducted by Sharlin et al., (1981) to investigate the
relative importance of ingestion of aflatoxin versus decreased feed consumption led to the
conclusion that even though decreased feed consumption did not produce symptoms of
Aflatoxins – Biochemistry and Molecular Biology](https://image.slidesharecdn.com/aflatoxins-biochemistryandmolecularbiology-141124075246-conversion-gate01/85/aflatoxinas-188-320.jpg)













































![224
G= green). Two other aflatoxins M1 and M2 were isolated from urine and milk and identified
as mammalian metabolites of AFB1 and AFB2 (Patterson et al., 1978).
Aflatoxins – Biochemistry and Molecular Biology
Fig. 2. Structure of aflatoxin
2.4.1 Physical properties
These four compounds were originally isolated by groups of investigators in England
(Nesbitt et al.,1962, Sargeant et al., 1961). The molecular formula of aflatoxin B1 was
established as C17H1206 and of aflatoxin G1 as C17H1207; aflatoxins B2 and G2 were found to
be the dihydro derivatives of the parent compounds, C17H1406 and C17H1407 (Hartley et al.,
1963). Some physical properties of the compounds are summarized in following Table 1.
Aflatoxin Molecular
Formula
Molecular
Weight
Melting Point
C [α]D23
B1
B2
G1
G2
C16H12O6
C17H14O6
C17H12O7
C17H14O7
312
314
328
330
268-269*
286-289*
244-246*
237-240*
-559
-492
-533
-473
*Decomposes
Table 1. Physical properties of aflatoxin](https://image.slidesharecdn.com/aflatoxins-biochemistryandmolecularbiology-141124075246-conversion-gate01/85/aflatoxinas-234-320.jpg)

















































![274
reducing, but not eliminating, the development of aflatoxins (Fandohan et. al., 2005; Turner
et. al., 2005). Moisture, insect and rodent control during storage can prevent damage to the
crop, which would promote aflatoxin development.
Aflatoxins often accumulate during food storage and therefore post-harvest control at the
subsistence farm aims to minimize fungal growth and aflatoxin production. The growth of
Aspergillus is influenced most critically by temperature, moisture content and storage time.
Studies conducted in Guinea, revealed a high HCC incidence and aflatoxin exposure mainly
attributable to contamination of groundnuts following storage. A primary prevention study
is underway where the intervention incorporates a package of post-harvest procedures,
including improved sun drying prior to storage, drying on cloth rather than directly on the
earth, removal of visibly mouldy nuts by hand sorting, storage in jute sacks rather than
plastic, use of wooden pallets for storage to avoid contact with the earth and to improve
ventilation and, finally, use of insecticides to control insect damage and spread of fungal
spores. The outcomes of the study are being determined by measuring both food levels of
the toxin and, more importantly, blood AF–albumin biomarker levels at three time points
post-harvest. Primary intervention strategies to reduce mycotoxin exposures at the post-harvest
Aflatoxins – Biochemistry and Molecular Biology
level may have a significant impact in high exposure populations, but are unlikely
to eliminate exposure. In addition, these approaches cannot be targeted specifically to high
risk individuals. Therefore, intervention strategies also encompass chemoprevention, using
compounds that interfere with the absorption or metabolism of aflatoxins once ingested
(Reviewed by Wild & Turner, 2002). From here derives the health sector.
9.2 Health sector
It refers basically to those kinds of food we can eat and how hygienically does food is
prepared.
Chemoprotection is one of the major used post-harvest techniques, and consists in the use of
chemicals (e.g. oltipraz [4-methyl-5-(2- pyrazinyl)-1,2-dithiole-3-thione], chloro- phylin) or
dietary intervention (e.g., eating broccoli sprouts, drinking green tea) to alter the
susceptibility of humans to carcinogens, and has been considered as a strategy to reduce the
risk of HCC in populations with high exposures to aflatoxins (Strosnider, 2006). The dietary
intervention is maybe the easiest way to prevent cancer disease; however, for many
communities in developing countries a change in diet is simply not feasible because they do
not have the culture of eating a balanced diet, joined to a great skepticism about eating
organic food, and moreover, that money isn´t enough to buy non-staple food.
Finally, is important to consider that simple food preparation methods such as sorting,
washing, crushing, and grain dehulling, may reduce aflatoxin levels (Fandohan et. al., 2005;
Park, 2002). In the case of maize, the fight against the fungal species has focused mainly
through processes such as nixtamalization in which product aflatoxins are eliminated
(Méndez & Moreno, 2009), or by the addition of low concentrations of Sodium Hydroxide
which achieves the elimination of a large amount of aflatoxins (Carrillo 2003). Aflatoxin
may be prevented by packing the dried products in polyethylene or propylene bags
(Siriacha, et. al., 1990).
Most efforts to address the mycotoxin problem involve analytic detection, government
regulation, and diversion of mycotoxin-contaminated commodities from the food supply.
Basic research on the biosynthesis and molecular biology of aflatoxins has been a priority
because a full understanding of the fundamental biological processes may yield new control
strategies for the abolition of aflatoxin contamination of food crops.](https://image.slidesharecdn.com/aflatoxins-biochemistryandmolecularbiology-141124075246-conversion-gate01/85/aflatoxinas-284-320.jpg)



![278
Fandohan P, Zoumenou D, Hounhouigan DJ, Marasas WF, Wingfield MJ, Hell K. (2005) Fate
Aflatoxins – Biochemistry and Molecular Biology
of aflatoxins and fumon- isins during the processing of maize into food products in
Benin. International Journal of Food Microbiology 98(3):249–259.
FAO. (1997) Food and Agricultural Organization of the United Nations Food and Nutrition
Paper 64. Worldwide Regulations for Mycotoxins. A Compendium, Rome.
FDA. (1988) Food and Drug Administration, USA. (1988) Action levels for added poisonous
or deleterious substances in food. Notice Fed. Register 53, 5043–5044.
Frisvad JC, Smedsgaard J, Larsen TO & Samson RA. (2004) Mycotoxins, drugs and other
extrolites produced by species in Penicillium subgenus Penicillium. Studies in
Mycology, 49:201–242.
Gimeno A. (2004) Aflatoxina M1 no leite. Riscos para a saúde pública, prevenção e controlo.
Alimentação Animal (Revista de la Associação Portuguesa dos Industriais de
Alimentos Compostos para Animais (IACA)), 49:32-44.
Greene HJ & Oehme FW. (1976) A possible case of equine aflatoxicosis. Clinical Toxicology
9, 251–254.
Groopman JD, Wogan GN, Roebuck BD & Kensler TW. (1994) Molecular biomarkers for
aflatoxins and their application to human cancer prevention. Cancer Research, 54,7-
1907s-1911s.
Groopman, JD, Kensler, TW & Wild CP. (2008) Protective Interventions to Prevent
Aflatoxin-Induced Carcinogenesis in Developing Countries. Annual Review of
Public Health, 29(1):187-203.
Guengerich FP, Johnsen WW, Ueng YF, Yamazaki H, Shimada T. (1996) Involvement of
cytochrome P450, glutathione S-transferase and epoxide hydrolase in the
metabolism of aflatoxin B1 and relevance to risk of human liver cancer.
Environmental Health Perspectives, 104: 557-562.
Hall AJ & Wild CP (1994). Epidemiology of Aflatoxin-Related Disease. In: The Toxicology of
Aflatoxins: Human Health, Veterinary, and Agricultural Significance. Eaton DL
and Groopman JD eds. San Diego, CA, Academic Press, Inc.: 233-258.
Helferich WG, Baldwin RL & Hsieh DPH. (1986) [14 C]-Aflatoxin B1 Metabolism in
Lactating Goats and Rats. Journal of Animal Science, 62:697-705.
Hendrickse R. (1999) Of sickturkeys, kwashiorkor, malaria, perinatal mortality, heroin
addicts and food poisoning: Research on the influence of aflatoxins on child health
in the tropics. Annals of Tropical Pediatrics, 19:229-36.
Hendrickse RG. (1991) Clinical implications of food contaminated by aflatoxins. Annals
Academy of Medicine Singapore, 20: 84-90.
Henry SH, Bosch FX & Bowers JC. (2002) Aflatoxin, hepatitis and worldwide liver cancer
risks. Advances in Experimental Medicine and Biology, 504:229–233.
Herzallah, SM. (2009) Determination of aflatoxins in eggs, milk, meat and meat products
using HPLC fluorescent and UV detectors. Food Chemistry, 114(3):1141-1146. .
Hesseltine CW. (1976) Conditions Leading to Mycotoxin Contamination of Foods Feeds. In:
Mycotoxins, Other Fungal Related Food Problems. Joseph V. Rodricks (Ed),
American Chemical Society, Washington DC. pp.1-22.
IARC. (2002) Some traditional herbal medicines, some mycotoxins, naphthalene and styrene.
Summary of data reported and evaluation. IARC Monographs on the evaluation of
the carcinogenic risk to humans. Vol. 82. International Agency for Research on
Cancer, Lyon, France.](https://image.slidesharecdn.com/aflatoxins-biochemistryandmolecularbiology-141124075246-conversion-gate01/85/aflatoxinas-288-320.jpg)


![Aflatoxins and Their Impact on Human and Animal Health: An Emerging Problem
281
Rizzi L, Simioli M, Roncada P & Zaghini A. (2003) Aflatoxin B1 and clinoptilolite in feed for
laying hens. Effect on egg quality, mycotoxin residues in livers and hepatic mixed
function oxidase activities. Journal of Food Protection, 66:860–865.
Rodricks JV & Stoloff L. (1977) Aflatoxin residues from contaminated feed in edible tissues
of feed producing animals. ]n: Mycotoxins in Human and Animal Health. Edited
by J. V. Rodricks, C. W. Hesseltine & M. A. Mehlman. Pathotox Publishers Inc.,
Park Forest South, IL, pp. 67.
Saad AM, Abdelgadir AM & Moss MO. (1995) Exposure of infants to aflatoxin M1 from
mothers’ breast milk in Abu Dhabi, UAE. Food Additives and Contaminants
12:255–261.
Saleemullah AI, Khalil IA, Shah H. (2006) Aflatoxin contents of stored and artificially
inoculated cereals and nuts. Food Chemistry, 98(2006):699-703.
Santella RM. (1999) Immunological methods for detection of carcinogen-DNA damage in
humans. Cancer Epidemiology, Biomarkers & Prevention, 8:733–39
Scholl PF, Turner PC, Sutcliffe AE, Sylla A, Diallo MS, et al. (2006) Quantitative comparison
of aflatoxinB1serum albumin adducts inhumansby isotope dilution mass
spectrometry and ELISA. Cancer Epidemiology, Biomarkers & Prevention15:823–
26.
Shephard GS. (2003) Aflatoxin and food safety: recent African perspectives. Journal of
Toxicology, 22(2&3):267–286.
Siriacha P, Kawashima K, Saito M, Tonboon Ek P & Buangsuwon D. (1990) Prevention of
Thai maize from the infection by Aspergillus flavus and aflatoxin contamination in
various packages. Source Proceedings of the Japanese Association of
Mycotoxicology. 32:41-46.
Smith EE, Phillips TD, Ellis JA, Harvey RB, Kubena LF, Thompson J & Newton G. (1994)
Dairy goat milk and effects on milk production and components Dietary Hydrated
Sodium Calcium Aluminosilicate Reduction of Aflatoxin M1 Residue in Dairy Goat
Milk and Effects on Milk Production and Components. Journal of Animal Science,
72:677-682.
Straw BE, D’Allaire S, Mengeling W & Taylor DJ. (1999) Disseases of Swine, Iowa State
University Press. AMES, Iowa, USA, 8th Edition, pp. 731-742
Strosnider H, Azziz-Baumgartner E, Banziger M, Bhat RV, Breiman R, et al. (2006). Public
Health Strategies for Reducing Aflatoxin Exposure in Developing Countries: A
Workgroup Report. Environmental Health Perspectives, 12:1898-1903.
Tedesco, D, Barbieri C, Lugano S & Garavaglia L. (2008) Aflatoxin contamination risk:
Bioactive natural compounds for animal health and healthy food. In B. F. A. Y.
Sinyavskiy, ed. Impact of pollution on Animal Products. pp. 177-184.
Turner PC, Sylla A, Gong YY, Diallo MS, Sutcliffe AE, Hall AJ, et al. (2005) Reduction in
exposure to carcinogenic aflatoxins by postharvest intervention measures in West
Africa: a community-based intervention study. Lancet 365(9475):1950–1956.
Unusan N. (2006) Ocurrence of aflatoxin M1 in UHT milk in Turkey. Food Chemical
Toxicology, 44:1897-1900.
Vaid J, Dawra RK, Sharma OP & Negi SS. (1981) Chronic aflatoxicosis in cattle. Veterinary &
Human Toxicology, 23(6):436-8](https://image.slidesharecdn.com/aflatoxins-biochemistryandmolecularbiology-141124075246-conversion-gate01/85/aflatoxinas-291-320.jpg)





![Aflatoxins: Mechanisms of Inhibition by Antagonistic Plants and Microorganisms
287
mammals) and environmental stresses like UV light and ozone (Bakkali et al. 2008; Korkina
2007). Plant bioactive metabolites can be divided into major groups including terpens
(terpenoids, isoterpenoids), phenylpropanoids (flavonoids, tannins, glycosides, and lignins),
phenolics and nitrogen-containing compounds (alkaloids and heterocyclic aromatics).
Search of natural sources for novel inhibitors of AF biosynthesis has been a subject of
intense study and a variety of bioactive AF inhibitory compounds have been reported from
medicinal plants (Review by Razzaghi-Abyaneh et al. 2010 and references therein).
3.1 Phenylpropanoids from Anethum graveolens and Petroselinum crispum
Anethum graveolens L. (dill) is a short-lived annual herb cultivated as a native plant in
southwest and central Asia including Iran. Petroselinum crispum (parsley) is a bright green
hairless biennial herbaceous plant in temperate climates, an annual herb in sub-tropical
and tropical areas. It is native to the central Mediterranean region including Iran,
southern Italy, Algeria and Tunisia and widely cultivated as a herb, a spice and a
vegetable. Several biological activities of both A. graveolens and P. crispum (Apiaceae
family) have been attributed to major constituents of the whole plants including
monoterpenes, flavonoids, furanocumarins and phenylpropanoids (Crowden et al. 1969).
Phenylpropanoids are a large class of plant phenols with a three-carbon side chain and a
phenyl ring derived from phenylalanine, an initial precursor, through shikimic acid
pathway (Korkina 2007). A large number of plant-derived phenolics including flavonoids,
cumarins and lignins are by-products of phenylpropanoid metabolism (MacRae &
Towers, 1984). Phenylpropanoids are involved in plant defense against pathogenic and
symbiotic microorganisms through cell wall strengthening and repair, direct antimicrobial
activity and coordinating signaling and chemotaxis pathways against naturally occurring
stressors. They are known for a wide range of biological activities from antimicrobial to
adaptogenic, neurotropic, immunostimulatory, antioxidant, antiulcer, anticancer and
antiproliferative properties (Korkina 2007 and references therein). In a recent study, we
reported the isolation of a phenylpropanoid compound named dillapiol, from leaf
essential oil of A. graveolens as specific inhibitor of AFG1 production by A. parasiticus with
an IC50 (50% inhibitory concentration) equal to 0.15 μM without obvious effect on fungal
growth and AFB1 synthesis (Razzaghi-Abyaneh et al. 2007). Another phenylpropanoid,
apiol, isolated from the seed essential oil of P. crispum in the same study showed similar
effects to dillapiol with an IC50 value of 0.24 μM for AFG1. It is proposed that these
phenylpropanoids may inhibit AFG1 biosynthesis via inhibition of CypA, a cytochrome
P450 dependent monooxygenase involved in conversion of O-methylsterigmatocystin to
AFG1 in AF biosynthetic pathway. More than 20 enzymes are involved in the formation of
AFB1, AFB2, AFG1, and AFG2. Among them, six are P450 monooxygenases, which include
OrdA, CypA, AvnA, CypX, VerA and VerB. AvnA is responsible for the conversion of
averantin to 5’-hydroxyaverantin (Yu et al., 1997) and CypX for the conversion of averufin
to hydroxyversicolorone (Wen et al., 2005). VerA and VerB are both involved in the
conversion of versicolorin A to demethylsterigmatocystin (Keller et al., 1994; Keller et al.,
1995). Cytochrome P450 monooxygenases belong to the superfamily of proteins that
contain a heme cofactor. The active site of a P450 is a heme-iron center. The iron is
tethered to the P450 protein via a thiolate ligand derived from a cysteine residue. This
cysteine heme-iron ligand signature, F[S/G/E] XGXRXCXG, is present at the N terminal
portion of the six P450s involved in AF biosynthesis. It is believed that OrdA and CypA
may correspond to the microsomal enzymes and NadA the cytosol enzyme that are](https://image.slidesharecdn.com/aflatoxins-biochemistryandmolecularbiology-141124075246-conversion-gate01/85/aflatoxinas-297-320.jpg)




![292
synthesis of enzymes in the early steps of AF biosynthetic pathway (Bhatnagar et al., 1988;
Zeringue and Bhatnagar, 1990). Allameh et al. (2001) did not find a positive correlation
between AF production and the activity of fatty acid synthase, a key enzyme involved in AF
production on neem-treated A. parasiticus. Razzaghi-Abyaneh et al. (2005) showed that AF
production at 96 h in cultures containing 50% neem leaf and seed extracts was inhibited by
90 and 65%, respectively. Electron microscopy examination of treated fungus and non-treated
Aflatoxins – Biochemistry and Molecular Biology
controls revealed an association between decreased AF production and
morphological changes suggesting that the integrity of cell barriers particularly cell wall is
crucial in the regulation of AF biosynthesis and excretion.
3.7 Caffeine: An alkaloid from cocoa and coffee beans
Caffeine is a xanthine alkaloid which was isolated from coffee in 1820 by a German chemist,
Friedlieb Ferdinand Runge. This compound also is found in different quantities in the beans,
leaves and fruits of some plants, and acts as a natural pesticide against plant pathogens.
Caffeine has been reported to inhibit fungal growth and mycotoxin (sterigmatocystin,
citrinin, patulin and ochratoxin A) production by some Aspergillus and Penicillium species
(Buchanan & Lewis, 1984 and references therein). Its mechanism of action was elucidated by
Buchanan & Lewis (1984). They observed nearly complete inhibition of AF production along
with a marked suppression (80-90%) in growth of A. parasiticus in submerged cultures
containing 2 mg/ml caffeine. Based on the results of the feeding experiments with [U-C14]
glucose and enzymatic assays, Buchanan & Levis proposed that caffeine blocks AF
production by affecting respiratory system of fungal cells and by inhibiting glucose uptake
which is necessary for the production of acetyl-CoA, the building block of AFs. It seems that
caffeine inhibits glucose uptake by directly affecting glucose transport system rather than
altering the level or activity of enzymes associated with the glucose metabolism.
3.8 Gallic acid from walnuts
Gallic acid is a phenolic compound and a key component of hydrolysable tannins found in
different plant species such as walnuts, oat bark and tea leaves. It is synthesized from an
early intermediate named 5-dehydroshikimate in shikimate pathway. Among diverse
biological activities reported for gallic acid, antimicrobial, antioxidant and antitumor
properties are involved in plant defense against environmental stressors and pathogens.
Inhibition of AF prduction by gallic acid without obvious effect on fungal growth was first
described by Cary et al. (2003). Investigation on the mechanisms of action of gallic acid has
shown that the compound affects AF biosynthesis by i) inhibition of the expression of AF
biosynthetic pathway genes nor1 and ver1 without affecting transcription of the regulatory
gene i.e. aflR, ii) disruption of the signal transduction pathway of oxidative stress system
and iii) suppression of expression of regulatory genes of AF biosynthetic pathway such as
laeA, whose expression is triggered by oxidative stress (Cary et al., 2003; Kim et al., 2005;
Mahoney & Molyneux, 2004).
3.9 Salicylaldehyde: A volatile natural plant compound
Salicylaldehyde is an aroma compound of Fagopyrum esculentum and other buckwheat
which acts as a key precursor of a variety of chelating agents with commercial importance.
Little has been documented about physiological roles and biological properties of this
volatile compound. Recently, Kim et al. (2010) showed that salicylaldehyde inhibits AF](https://image.slidesharecdn.com/aflatoxins-biochemistryandmolecularbiology-141124075246-conversion-gate01/85/aflatoxinas-302-320.jpg)




























![The Evolutionary Dynamics in the Research on Aflatoxins During the 2001-2010 Decade
321
Sanyal, A.J., Yoon, S.K. & Lencioni, R. (2010). The etiology of hepatocellular carcinoma and
consequences for treatment. The Oncologist Vol. 15 Suppl 4, pp. 14-22, ISSN 1549-
490X (Electronic), 1083-7159 (Linking)
Sghaier, M.B., Boubaker, J., Neffati, A., Limem, I., Skandrani, I., Bhouri, W., Bouhlel, I.,
Kilani, S., Chekir-Ghedira, L. & Ghedira, K. (2010). Antimutagenic and antioxidant
potentials of Teucrium ramosissimum essential oil. Chem Biodivers Vol. 7, No. 7,
(Jul), pp. 1754-1763, ISSN 1612-1880 (Electronic), 1612-1872 (Linking)
Stenske, K.A., Smith, J.R., Newman, S.J., Newman, L.B. & Kirk, C.A. (2006). Aflatoxicosis in
dogs and dealing with suspected contaminated commercial foods. J Am Vet Med
Assoc Vol. 228, No. 11, (Jun 1), pp. 1686-1691, ISSN 0003-1488 (Print), 0003-1488
(Linking)
Sugita-Konishi, Y., Sato, T., Saito, S., Nakajima, M., Tabata, S., Tanaka, T., Norizuki, H., Itoh,
Y., Kai, S., Sugiyama, K., Kamata, Y., Yoshiike, N. & Kumagai, S. (2010). Exposure
to aflatoxins in Japan: risk assessment for aflatoxin B1. Food Addit Contam Part A
Chem Anal Control Expo Risk Assess Vol. 27, No. 3, (Mar), pp. 365-372, ISSN 1944-
0057 (Electronic), 1944-0057 (Linking)
Theumer, M.G., Canepa, M.C., Lopez, A.G., Mary, V.S., Dambolena, J.S. & Rubinstein, H.R.
(2010). Subchronic mycotoxicoses in Wistar rats: assessment of the in vivo and in
vitro genotoxicity induced by fumonisins and aflatoxin B(1), and oxidative stress
biomarkers status. Toxicology Vol. 268, No. 1-2, (Jan 31), pp. 104-110, ISSN 1879-3185
(Electronic), 0300-483X (Linking)
Theumer, M.G., Lopez, A.G., Masih, D.T., Chulze, S.N. & Rubinstein, H.R. (2003).
Immunobiological effects of AFB1 and AFB1-FB1 mixture in experimental
subchronic mycotoxicoses in rats. Toxicology Vol. 186, No. 1-2, (Apr 15), pp. 159-170,
ISSN 0300-483X (Print), 0300-483X (Linking)
Wang, J., Ogata, M., Hirai, H. & Kawagishi, H. (2011). Detoxification of aflatoxin B1 by
manganese peroxidase from the white-rot fungus Phanerochaete sordida YK-624.
FEMS Microbiology Letters Vol. 314, No. 2, (Jan), pp. 164-169, ISSN 1574-6968
(Electronic), 0378-1097 (Linking)
Whittaker, S., Marais, R. & Zhu, A.X. (2010). The role of signaling pathways in the
development and treatment of hepatocellular carcinoma. Oncogene Vol. 29, No. 36,
(Sep 9), pp. 4989-5005, ISSN 1476-5594 (Electronic), 0950-9232 (Linking)
Wojnowski, L., Turner, P.C., Pedersen, B., Hustert, E., Brockmoller, J., Mendy, M., Whittle,
H.C., Kirk, G. & Wild, C.P. (2004). Increased levels of aflatoxin-albumin adducts are
associated with CYP3A5 polymorphisms in The Gambia, West Africa.
Pharmacogenetics Vol. 14, No. 10, (Oct), pp. 691-700, ISSN 0960-314X (Print), 0960-
314X (Linking)
Xu, J., Wang, H., Ji, R. & Luo, X. (2003). [Study on the effect of the growth and aflatoxin
production by Aspergillus flavus parasiticus NRRL 2999 in the present of
Lactobacillus plantarum ATCC 8014]. Wei Sheng Yan Jiu Vol. 32, No. 4, (Jul), pp.
334-338, ISSN 1000-8020 (Print), 1000-8020 (Linking)
Zachariasova, M., Cajka, T., Godula, M., Malachova, A., Veprikova, Z. & Hajslova, J. (2010).
Analysis of multiple mycotoxins in beer employing (ultra)-high-resolution mass](https://image.slidesharecdn.com/aflatoxins-biochemistryandmolecularbiology-141124075246-conversion-gate01/85/aflatoxinas-331-320.jpg)
![Aflatoxins – Biochemistry and Molecular Biology
322
spectrometry. Rapid Communications in Mass Spectrometry Vol. 24, No. 22, (Nov 30),
pp. 3357-3367, ISSN 1097-0231 (Electronic), 0951-4198 (Linking)
Zhang, L., Ye, Y., An, Y., Tian, Y., Wang, Y. & Tang, H. (2011). Systems responses of rats to
aflatoxin B1 exposure revealed with metabonomic changes in multiple biological
matrices. J Proteome Res Vol. 10, No. 2, (Feb 4), pp. 614-623, ISSN 1535-3907
(Electronic), 1535-3893 (Linking)
Zhang, X.H. & Chen, J.M. (2004). [Comparison between the post-column derivatization with
bromine by HPLC and the fluorometric analysis for determination of aflatoxins in
medicinal herbs and plant extracts]. Yao Xue Xue Bao Vol. 39, No. 12, (Dec), pp. 997-
1000, ISSN 0513-4870 (Print), 0513-4870 (Linking)](https://image.slidesharecdn.com/aflatoxins-biochemistryandmolecularbiology-141124075246-conversion-gate01/85/aflatoxinas-332-320.jpg)





![328
If the process needs so little time (one minute), it could suggest that neither the entrance of
AFB1 into cell nor its metabolic conversion is necessary, therefore microorganism cell wall
components may be involved in aflatoxin B1 remotion, as was suggested by various authors
(Haskard et al., 2001; Karaman et al., 2005; Lahtinen et al., 2004; Raju & Devegowda, 2000).
Aflatoxins – Biochemistry and Molecular Biology
2.1.2 Mycotoxin and microorganisms concentration
Effects of different AFB1 concentration on toxin removal by LAB and yeast strains are shown
in figure 1. Regardless of the studied strain, mycotoxin binding was dependent of its solution
concentration and was always lineal at low values of AFB1 and showed the transition to a
plateau with higher toxin concentrations. The amount of toxin removed increased with
increasing AFB1 concentration, but the percentage removed decreased with increasing toxin
concentration, because the saturation started. This behaviour strongly suggests that the
microorganisms have a limited number of sites to bind AFB1 either as free or occupied sites.
0,0 2,5 5,0 7,5 10,0 12,5 15,0 17,5 20,0
4,0
3,5
3,0
2,5
2,0
1,5
1,0
0,5
[AFB1] (ug ml-1)
AFB1 bound (ug)
45
A B
0,0 2,5 5,0 7,5 10,0 12,5 15,0 17,5 20,0 22
40
35
30
25
20
15
10
5
% AFB1 bound
[AFB1] (ug ml-1)
Fig. 1. (A) Adsorption isotherms of AFB1 by Lactobacillus acidophilus 24 ( ) and Saccharomyces
cerevisiae 01 ( ). Aliquots of 1 ml of cells (3 x 108 CFU ml-1) for L. acidophilus 24 and (1 x 107
CFU ml-1) for S. cerevisiae 01, were suspended in PBS in the presence of AFB1 at the following
concentrations: 2.5; 5.0; 7.5; 10.0; 15.0 and 20.0 μg ml-1. AFB1 binding to cells was performed
as described in Table 1. (B) AFB1 binding expressed as a percentage of the amount of
mycotoxin present in the medium. Data are means from triplicate experiments.
Lee et al. (2003) refer to AFB1 binding as a process of very high-affinity, linear relation with
the toxin concentration used, and therefore, the amount of AFB1 bound should be
“limitless”; in other words they conclude that the bacterial surface does not have a defined
number of binding sites. Our results do not support this idea. An important difference could
be the number of microorganisms used in the experiments (1010 for Lee et al. and 108 for us),
including more than a hundred times higher than ours for similar concentrations of AFB1, so
that the saturation phenomenon could not be observed.
When a growing number of microorganisms were suspended in PBS in the presence of a
fixed AFB1 concentration, we observed that the increase in bacterial or yeast concentration
also reported an increase in AFB1 binding, but it was never sufficient to bind all toxins
present in the medium. Figure 2 shows the results with Lactobacillus casei subsp. rhamnosus
which are similar to those obtained with all LAB and yeast strains we analysed.](https://image.slidesharecdn.com/aflatoxins-biochemistryandmolecularbiology-141124075246-conversion-gate01/85/aflatoxinas-338-320.jpg)



![332
Thus, to determine the AFB1 binding with three different samples: i) whole cells of
S. cerevisiae CECT 1891 (cells control), ii) spheroplasts from cell control and iii) a concentrate
of the supernatant from spheroplasts corresponding to 107 cells, was possible.
As Table 7 shows, neither spheroplasts nor its supernatant were able to remove AFB1 from
liquid medium, since very low uptake rates not even changed when the concentration of
aflatoxin B1 in the medium was increased 10 times, suggesting that these binds were
nonspecific.
These results confirm that the compounds involved in AFB1 binding to yeast, are
components of the cell wall and that it must keep its structure in order to remove AFB1
effectively. Similar results were reported by Hernandez-Mendoza et al. (2009), who
demonstrated that the data obtained in binding assays with bacterial cell wall indicated that
these purified fragments effectively bind AFB1 as reported previously by Lahtinen et al.
(2004). Furthermore, loss of the bacterial cell wall in response to treatments with enzymes
showed a reduction in AFB1 binding capacity relative to that of whole cells. These results
demonstrate the importance of cell wall integrity in binding AFB1 by LAB strains, and
confirm the role of a cell wall-related physical phenomenon as opposed to a metabolic
degradation reaction.
Aflatoxins – Biochemistry and Molecular Biology
2.1.6 Mechanism proposed for the interaction between Aflatoxin B1 with yeast and
lactic acid bacteria strains
According to an integrated synthesis of the results reported above, it is clear that: (i) the
removal and release of toxins is a fast and reversible process, (ii) this process does not
involve AFB1 chemical modification, (iii) the amount of AFB1 removed is toxin- and cell
concentration-dependent, (iv) the same result is obtained with viable and nonviable (heat-treated)
cells and (v) the cell wall of the microorganism integrity is necessary for the
"binding" mechanism between AFB1 and the cells. Briefly, the process involved is, by nature,
reversible and fast kinetic. Accordingly, this process can be analyzed as a PHISICAL
ADSORPTION (physisorption), and probably the binding forces involved are a weak Van
der Waals type, hydrogen bonds, or hydrophobic interaction.
Following this an adsorption phenomenon to the external microorganism surface to explain
AFB1 binding is proposed (Figure 3). This model considers the attachment of AFB1
molecules to the microorganism surface. The relationship between the amounts of the AFB1
at the microorganism surface as a function of its solution concentration is described by an
adsorption isotherm. The shape of the isotherm shows linearity at low values of AFB1 and
then shows the transition to a plateau (Figure 4A). This type of isotherm can be described by
the following equation:
Adsorption = M [AFB1]eq x Keq / 1 + [AFB1]eq Keq (Figure 3)
where M is the maximum number of adsorption sites per microorganism, and Keq
(expressed in liters per mole) is equivalent to the affinity (or cohesion force) of AFB1
molecules for the adsorption sites. The linearized form of the isotherm is the double-reciprocal
plot from the saturation curve (1/adsorption = 1/[AFB1]eq 1/M Keq + 1/M), as
shown in Figure 4B. From the slope and interception of the resulting line, factors M and Keq
can be determined. The most efficient microorganism would be that having maximal M and
Keq values. Note that this physisorption model does not discriminate between viable and
nonviable cells, i.e., cell concentrations should be determined by a hemocytometer instead of
CFU per milliliter.](https://image.slidesharecdn.com/aflatoxins-biochemistryandmolecularbiology-141124075246-conversion-gate01/85/aflatoxinas-342-320.jpg)
![Binding of Aflatoxin B1 to Lactic Acid Bacteria and
Saccharomyces cerevisiae in vitro: A Useful Model to Determine the Most Efficient Microorganism
333
AFB1 + S S-AFB1
[S-AFB1] Xso
Keq = =
[AFB1] [S] [AFB1] Xsf
Xso + Xsf = 1 and Ø = Xso
Xsf = 1 – Ø and Keq = Ø / [AFB1] (1 –Ø)
Ø = [AFB1] Keq / 1 + [AFB1] Keq
M [AFB1] Keq
Adsorption = M x Ø and Adsorption =
1 + [AFB1] Keq
1 / adsorption = 1 / [AFB1]eq 1 / M Keq + 1 / M
Fig. 3. Theoretical model proposed to explain the adsorption process of AFB1 by LAB and S.
cerevisiae. The equations permit the calculation of the total binding sites per microorganism
(M) and the equilibrium constant (Keq) involved in the process. Sf is the amount of free sites
in the surface cellular. So represents the occupied sites in the cell surface and is equivalent to
S-AFB1, determined as the AFB1 bound to the cell. [AFB1] is the AFB1 concentration in the
equilibrium condition of the system, determined as the free AFB1 in the medium. Xso (Ø) is
the molar fraction of occupied sites (mol So/mol total). Xsf (1 - Ø) is the molar fraction of
free sites (mol Sf/mol total). Adsorption is the amount of molecules of AFB1 bound per cell
(M x Ø).
Figure 4A shows the saturation curve of L. acidophilus Po22 and L. fermentum subsp.
cellobiosus 408 when the process is considered physisorption and indicates that the two
strains have similar AFB1 binding efficiency per bacterium, particularly for low
concentrations of toxin. This result is different from the ones reported in Table 1 based only
on viable bacteria (CFU ml-1) and assayed with a unique mycotoxin concentration, since L.
acidophilus Po22 was more efficient in AFB1 binding (42.8%) than L. fermentum subsp.
cellobiosus 408 (13.2%). However, we determined that in these assays Po22 strain had more
dead cells than 408 strain, consequently Po22 had more total cells and showed higher
percentage of AFB1 binding. In terms of our proposed adsorption model, L. fermentum
subsp. cellobiosus 408 has lower M values but higher Keq values than L. acidophilus Po22 (Table
8), and these two factors balance to give toxin adsorption efficiencies of 9.37 and 6.25 x 1010
respectively.
According to adsorption model, a larger cell surface is associated with higher total sites per
cell (M). To test this possibility, we measured AFB1 adsorption in three yeast strains and the
saturation curves are shown in Figure 5.
The adsorption of AFB1 by S. cerevisiae RC016 (from pig gut), S. cerevisiae RC008 (from
feed stuff) and S. cerevisiae CECT 1891 (from culture collection) was dependent on the
toxin concentration in the medium, which is similar to the results showed in Figure 1 by](https://image.slidesharecdn.com/aflatoxins-biochemistryandmolecularbiology-141124075246-conversion-gate01/85/aflatoxinas-343-320.jpg)
![334
S. cerevisiae 01 and L. acidophilus 24. The data from Figure 5 were employed to construct
the respective adsorption isotherms to obtain the M and Keq values for these systems, and
they are shown in Table 8. The M values were 25- to 1,000-fold higher for the yeast strains
than for the bacteria, whereas Keq values were similar, as differences never exceeded
3 times. Thus, the yeast strains respect to bacterial strains, showed a ~50-300-fold higher
efficiency to AFB1 removal from the medium, mainly for their high M values.
Aflatoxins – Biochemistry and Molecular Biology
2,5
2,0
1,5
1,0
0,5
(bacteria molecule-1 ) ( X 10-6 )
1 / adsorption
-5 0 5 10 15 20 25
1 / [AFB1]eq
(ml molecule-1) (x10-17)
0,0 2,5 5,0 7,5 10,0 12,5 15,0
5
4
3
2
1
adsorption
[AFB1]eq
-1) (x1016)
(molecule ml
( molecules of AFB 1 bacteria -1 ) ( X106 )
A B
Fig. 4. Adsorption isotherms of AFB1 by L. fermentum 408 ( ) and L. acidophilus Po22 ( ).
Aliquots of 1 ml of cells (0.89 x 109 cells for L. fermentum 408; 1.20 x 109 cells for
L. acidophilus Po22) were suspended in PBS in the presence of AFB1 at the following
concentrations: 0.5; 1.0; 2.5; 5.0 and 10.0 μg ml-1. Then, the bacteria were incubated for
30 min at 37°C and pelleted by centrifugation. The supernatant was collected for free
AFB1 analysis by HPLC according to Bueno et al. (2007). AFB1 bound to cells was
calculated as the difference between the total AFB1 and the amount of free AFB1. The
adsorption was calculated as the ratio between the molecules of AFB1 bound to cells
and the amount of cells in the incubation medium. The [AFB1]eq was equivalent to the
free AFB1. (A) Saturation curve. (B) Inverse plot of the same data as (A). Data are means
from triplicate experiments.
Lee et al. (2003) described an adsorption process by three different bacteria strains, in viable
and nonviable forms, as a function of AFB1 concentration. For comparative purposes, we
applied our theoretical model to the data of Lee et al. (Table 8, lines 3 through 5), and the M
and Keq values for their three LAB strains were calculated. L. rhamnosus LC- 705 had the
most efficient AFB1 removal. However, all three strains were less efficient than P22 and 408,
mainly because they had smaller M values. Strain LGG-V of Lee et al. was 10-fold less
efficient than 408, since its M value was 10-fold smaller as well (Table 8).
We proposed a theoretical model of adsorption applicable to microorganisms that bind
AFB1 and this model allows an estimation of the number of aflatoxin B1 binding sites per
microorganism (M), the system equilibrium constant (Keq), and the efficiency of cells to
remove AFB1 from liquid medium (M x Keq). We analyzed three systems: two Lactobacillus
strains (L. acidophilus Po22 and L. fermentum subsp. cellobiosus 408) no tested before, three](https://image.slidesharecdn.com/aflatoxins-biochemistryandmolecularbiology-141124075246-conversion-gate01/85/aflatoxinas-344-320.jpg)
![Binding of Aflatoxin B1 to Lactic Acid Bacteria and
Saccharomyces cerevisiae in vitro: A Useful Model to Determine the Most Efficient Microorganism
335
0 5 10 15 20
6
5
4
3
2
1
AFB1 bound (μg)
[AFB1] (μg ml-1)
Cells, at the concentration indicated, were suspended in 1 ml of PBS with different AFB1 concentrations
(1; 5; 10; 15; 20 μg ml-1) and incubated for 30 min at 37°C. AFB1 binding to cells was performed as
described in Fig. 1. Data are means ± standard deviations for triplicate samples.
Fig. 5. AFB1 binding upon exposure to S. cerevisiae CECT 1891 (1 x 107 cells ml-1) ( ), S.
cerevisiae RC008 (4.8 x 107 cells ml-1) ( ), S. cerevisiae RC016 (2.5 x 107 cells ml-1) ( ).
Strains M
(1x106 sites cell-1)
Keq
(1x104 M-1)
Efficiency
(1x1010)
L. acidophilus Po22 8.33 0.75 6.25
L. fermentum subsp. cellobiosus 408 6.25 1.50 9.37
LC705-NV 1.48 3.12 4.62
PJS-NV 1.00 2.80 2.80
LGG-V 0.64 1.40 0.89
S. cerevisiae RC016 580.00 0.80 460.00
S. cerevisiae RC008 200.00 2.20 440.00
S. cerevisiae CECT 1891 1,000.00 3.12 3,120.00
Table 8. Total binding sites per microorganism (M), equilibrium constant (Keq) and efficiency
(M x Keq) for different strains. M, Keq and M x Keq for various microorganisms were
calculated by linear regression by the following equation: 1/adsorption = (1/[AFB1]) x 1/M
x Keq + 1/M, as described in Fig. 3. The data for linear regression construction were extracted
from Fig. 4A for L. acidophilus Po22 and L. fermentum subsp. cellobiosus 408 strains, from Fig. 5
for S. cerevisiae strains and from Fig. 1 from Lee et al. (2003) for LC705-NV (Lactobacillus
rhamnosus strain, nonviable cells), PJS-NV (Propionibacterium freudenreichii subsp. Shermanii
JS, nonviable cells), and LGG-V (L. rhamnosus GG, viable cells).
yeast strains (S. cerevisiae RC016, S. cerevisiae RC008 and S. cerevisiae CECT 1891) no studied
before either, and LAB studied by another laboratory (Lee et al. 2003). The most efficient
microorganism was S. cerevisiae CECT 1891, mainly because binds more AFB1 per cell (Table
8). As we mentioned before, in AFB1 binding to the yeast, the main components involved are
cell wall glucomannans (Karaman et al., 2005), whereas cell wall peptidoglycans are
responsible for AFB1 removal by LAB (Lahtinen et al., 2004). Unexpectedly, bacteria and](https://image.slidesharecdn.com/aflatoxins-biochemistryandmolecularbiology-141124075246-conversion-gate01/85/aflatoxinas-345-320.jpg)


![338
The ability to survive gastrointestinal simulated conditions is an absolute need of probiotic
microorganisms, and it is generally included among the criteria used to select potential
probiotic strains (Morelli, 2000). In this work, all the assayed strains were able not only to
resist gastrointestinal passage but also to grow under these conditions. Other authors have
reported the same results with S. cerevisiae strains isolated from infant faeces and feta cheese
(Psomas et al., 2001) and with S. cerevisiae var boulardii strain isolated from food (van der Aa
Kuhle et al., 2005). However, the use of bacteria has demonstrated a very low recovery after
being subjected to these gastrointestinal in vitro conditions (Gusils et al., 2002). Lin et al.
(2007) reported a 2 or 3 log decrease in Lactobacillus fermentum strains isolated from swine
and poultry. In agreement with our results, Pennacchia et al. (2008) reported that more than
50% of S. cerevisiae strains exposed to simulated passage through the human GI tract,
showed 70% survival.
Aflatoxins – Biochemistry and Molecular Biology
2.2.2 Auto-aggregation assay
Table 10 shows the auto-aggregation ability of the tested S. cerevisiae strains. Results showed
that RC008, RC009 and RC016 strains exhibited a strong auto-aggregation score while RC012
strain exhibited weak auto-aggregation. This ability, or formation of multicellular clumps
between microorganisms of the same strain, is a measure of the adhesion ability to epithelial
cells and could be related to biofilm formation. The percentages of auto-aggregation
obtained ranged from 85.3 to 97.9%, indicating that all strains showed an auto-aggregative
phenotype.
S. cerevisiae
Strains OD600 (t0)1 OD600 (t1)2 [1- (OD600 t1 / OD600 t0)] x 100 % Aggregation
Score3
RC008 1.144 0.088 92.3 ++
RC009 1.173 0.025 97.9 ++
RC012 0.974 0.144 85.3 +
RC016 1.099 0.079 92.9 ++
1Cells were harvested by centrifugation and suspended in PBS to optical density ~1 (O.D.) units at
600 nm. 2Optical density of the upper suspension (O.D.) units at 600 nm after incubation at 37ºC for 2 h.
3 (++) strong; (+) weak; (-) negative
Table 10. Auto-aggregation ability of Saccharomyces cerevisiae strains
2.2.3 Adhesion assay
The number of yeast cells adhesive to 100 Vero cells at different inoculums sizes of S.
cerevisiae is shown in Table 11.
Results indicate that the adhesion ability of yeasts varied among strains according to the
density of yeast cells. At 106 cells ml-1 the strains showed different adhesion ability: some of
them had high adhesion capability while in others it was low. At 107 cells ml-1 all strains
showed a similar strong adhesive ability to Vero cells. Adhesion ability of probiotcs to
intestinal mucus and to enterocytes is an important prerequisite for transient colonization of
the host intestinal tract. Adhesion to the mucosa is also considered to be an important factor
for modulation of the immune system and for antagonistic activity against enteropathogens](https://image.slidesharecdn.com/aflatoxins-biochemistryandmolecularbiology-141124075246-conversion-gate01/85/aflatoxinas-348-320.jpg)

































































































































